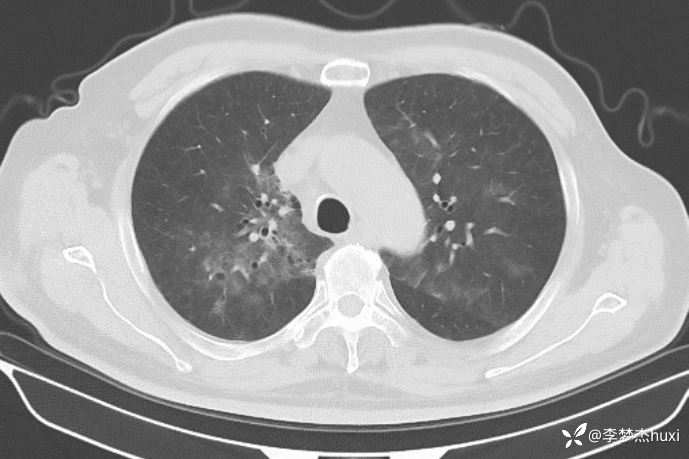
img

男性74岁,莫西沙星治疗加重的肺炎,可能什么病原菌?
 离床医学离床医学等 2人推荐
离床医学离床医学等 2人推荐患者性别:男
患者年龄:74
主诉:主因咳嗽3天于2024-01-12 18:05入院 。
简要病史: 患者缘于入院前3天无明显诱因出现咳嗽,无痰,无喘息,无憋气,无心悸,无头痛、头晕,无咽痛,无鼻塞、流涕,无胸痛,无恶心、呕吐,无腹痛、腹泻,无尿频、尿急、尿痛,院外未治疗,为诊治来我院,以“肺恶性肿瘤”收住院。
既往史:既往高血压病史 20 余年,最高 180/90mmHg,平素口服降压零号治疗,控制可;糖尿病病史 20 余年,平素应用诺和灵 30R,控制良好;右肺鳞癌病史11月,放疗结束3天,期间放射性食管炎,目前仍吞咽痛;否认冠心病病史;否认“肝炎”、“结核”等传染病史;否认外伤史,否认手术史,无输血史,否认药物、食物过敏史;预防接种史不详,系统回顾无特殊。。
体格检查: 查体:T37.7℃,P68次/分,R20次/分,BP120/70mmHg。神清,呼吸平稳,浅表淋巴结不大,双肺未闻及干湿性啰音,心律齐,无杂音,腹软,无压痛,双下肢无水肿。
辅助检查:
临床诊断:感染性发热。
治疗经过:莫西沙星、喜炎平治疗进展
讨论:可能什么病原体?